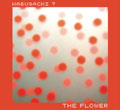

画像をもっと見る(全1枚)
The Flower+The Radio
レーベル
:
intoxicate records
規格品番
:
INTD-1012
フォーマット
:
CD
バーコード
:
4997184885294
国
:
日本 - Japan
発売日
:
2007年4月19日
収録内容
CD
1
The Arrow
2
People
3
Water
4
Love
5
The Crack
6
El Angel
7
La Casa
8
El Viento
9
La Luz
10
El Mundo Anfibio
11
Downtown (Interval I)
12
El Glaciar (Parte I)
13
Una Trade En El Abasto
14
El Glaciar (Parte II)
15
La Paz
16
17
The Veil
18
Pictured Laughing
19
The Fool
20
Vera (Interval II)
21
The Eagle And Thecrow
22
The Village
23
Nazareno Cruz Y El Buho
24
The Joyful Adventure
CD
1
La flor maravillosa
2
Night
3
The roaring of lions
4
Walking no more
5
The Radio
6
Un trofeo en el cielo
7
The voice
8
Every cry of every man
9
Scratch
10
The good old days
11
The other side of beauty
12
La hierba roja
13
The crawler
14
Somewhere between magic and life
15
Jungle zoo
16
Bolivia
クレジット
アーティスト:Fernando Kabusacki
リリース概要
<商品の情報>
これまでに5枚のソロ作を発表し、フアナ・モリーナ来日の際のサポートをはじめ、ROVO、ボアダムス、Buffalo Daughter、UA…など、東京とブエノスアイレスを繋ぐキーパーソン、世界中のアンダーグラウンド・シーンとコミットする ”アルゼンチン音響派”の最重要人物フェルナンド・カブサッキによる通算6枚目となるアルバム。人の温もりを感じさせるアコースティック・サウンドからミニマリスティックなトラック、まるで湧き出る泉のような心地良いサウンドから哀愁さと儚さ、切なさが共存した旋律など、その曲ごとに様々な表情を見せるカラフルな音絵巻が綴られる。
これまでに5枚のソロ作を発表し、フアナ・モリーナ来日の際のサポートをはじめ、ROVO、ボアダムス、Buffalo Daughter、UA…など、東京とブエノスアイレスを繋ぐキーパーソン、世界中のアンダーグラウンド・シーンとコミットする ”アルゼンチン音響派”の最重要人物フェルナンド・カブサッキによる通算6枚目となるアルバム。人の温もりを感じさせるアコースティック・サウンドからミニマリスティックなトラック、まるで湧き出る泉のような心地良いサウンドから哀愁さと儚さ、切なさが共存した旋律など、その曲ごとに様々な表情を見せるカラフルな音絵巻が綴られる。
バージョンリスト
タイトル
フォーマット
レーベル
規格品番
国
発売年
コレクション いいね!ランキング